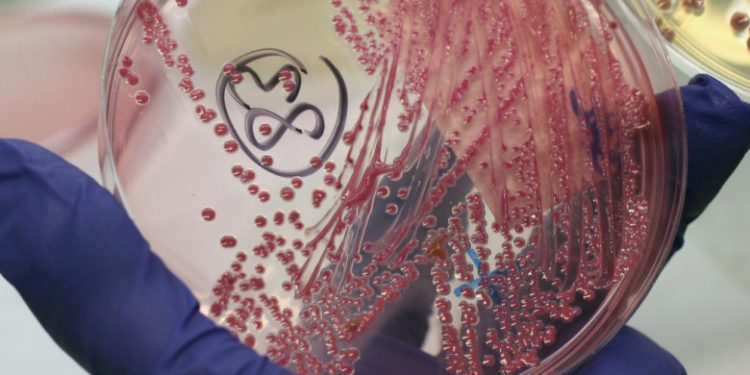
Ce este bruceloza, noua epidemie care a izbucnit în China, după o scurgere de la o fabrică biofarmaceutică

Mii de oameni din nord-vestul Chinei au fost testați pentru o boală bacteriană, bruceloza, într-un focar cauzat de o scurgere la o companie biofarmaceutică, relatează CNN.
Comisia de sănătate din Lanzhou, capitala provinciei Gansu, a confirmat că 3.245 de persoane au bruceloză, care este de obicei cauzată de contactul cu animalele care transportă bacteriile brucella, scrie digi24.ro.
Alte 1.401 de persoane au avut teste preliminare pozitive. În total, autoritățile au testat 21.847 de persoane din cei 2,9 milioane de locuitori ai orașului.
Nu au fost raportate decese, a anunțat Comisia de Sănătate a orașului.
Ce simptome are bruceloza
Bruceloza, cunoscută și sub denumirea de febră malteză sau febră mediteraneană, poate provoca dureri de cap, dureri musculare, febră și oboseală. Uneori simptomele dispar, dar sunt și cazuri în care pot deveni cronice sau nu pot dispărea niciodată, cum ar fi artrita sau umflarea anumitor organe, potrivit Centrului pentru Controlul și Prevenirea Bolilor (CDC) din Statele Unite.
Cum se produce infectarea cu brucella
Transmiterea brucelozei de la om la om este extrem de rară, potrivit CDC. Cei mai mulți oameni se infectează prin consumul de alimente contaminate sau inspirând bacteria, ceea ce pare să se fi intâmplat în Lanzhou.
Focarul a fost provocat de o scurgere produsă la fabrica biofarmaceutică Zhongmu Lanzhou, care a avut loc în vara anului trecut, potrivit Comisiei de sănătate a orașului. Compania care producea vaccinuri anti-brucella pentru uz animal a folosit dezinfectanți și produse igienice expirate, ceea ce înseamnă că nu toate bacteriile au fost eradicate în gazele reziduale.
Cum a ajuns bacteria la oameni
Acest gaz rezidual contaminat a format aerosoli care conțineau bacteriile care și s-au scurs în aer, transportați de vânt până la Institutul de cercetare veterinară din Lanzhou, unde au fost înregistrate primele cazuri.
Angajații institutului au început să raporteze infectări în noiembrie, iar numărul cazurilor a crescut rapid. Până la sfârșitul lunii decembrie, cel puțin 181 de persoane de la institut fuseseră infectate cu bruceloză, potrivit agenției de știri chineze Xinhua.
De asemenea, au fost infectați studenți și angajați ai universității din Lanzhou; infecția s-a răspândit și în provincia Heilongjiang, la extremitatea nord-estică a țării, unde 13 cazuri pozitive au fost confirmate în institutul veterinar în august.
Fabrica biofarmaceutică, sancționată
În lunile care au urmat, oficialii locali au lansat o anchetă cu privire la scurgerea din fabrică. În ianuarie, autoritățile au revocat licențele de producție a vaccinului pentru fabrica de la care a porni totul.
Acum, Comisia de sănătate Lanzhou a anunțat că 11 spitale publice vor oferi controale gratuite și regulate pentru pacienții infectați. Raportul nu a oferit detalii suplimentare cu privire la compensațiile oferite pacienților, spuând doar că vor fi plătite pe grupe, începând de luna viitoare.
Bruceloza era frecventă în China în anii 1980, deși de atunci a scăzut numărul cazurilor, după apariția vaccinurilor și dtorită unui control mai bun al infectărilor. Totuși, în ultimele decenii a existat o explozie de focare de bruceloză în întreaga lume. De exemplu, un focar izbucnit în Bosnia a dus la infectrea a circa 1.000 de persoane în 2008. În SUA, focarele de bruceloză au costat guvernul federal și industria zootehnică miliarde de dolari. Aproximativ 60% dintre femelele bizoni din Parcul Național Yellowstone sunt purtătoare ale bacteriei, potrivit reprezentanților parcului.